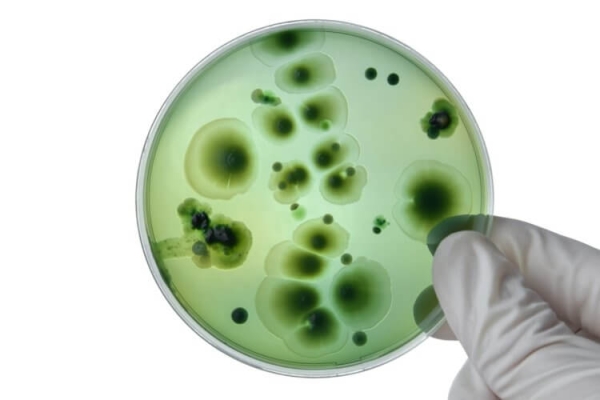
В мире растет количество грибковых инфекций. Почему это происходит и чем грозит? - Hi-News.ru
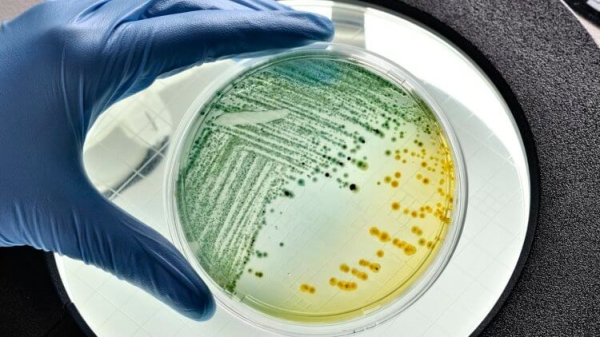
В мире растет количество грибковых инфекций. Почему это происходит и чем грозит? - Hi-News.ru

По мере того, как средняя температура на планете растет, а число аномально жарких дней увеличивается, некоторые виды животных и растений приспосабливаются к меняющейся окружающей среде. Недавно в работе, опубликованной в журнале The Lancet Microbe, исследователи сообщили о наибольшем успехе грибов в адаптации к более теплому климату. Но не просто грибов – речь идет о патогенных представителях этого царства. В статье говорится, что патогенные виды грибов проявляют признаки повышенной активности и вирулентности. При этом большинство грибов обладают низкой термоустойчивостью, а значит не могут выживать при температуре тела млекопитающих. А вот новые виды, такие как Candida auris, напротив, устойчивы к высоким температурам и адаптируются к температуре тела человека. Полученные в ходе анализа данные свидетельствуют о том, что количество микозов – грибковых заболеваний – в мире будет постоянно расти.

Влияние изменения климата и стихийных бедствий на грибковые инфекции. Изображение: www.futurity.org
Патогенные грибы широко распространены в окружающей среде – они присутствуют на растениях, одежде, предметах домашнего обихода, в почве. Заболевания, вызываемые патогенными грибами называют микозами.
Изменение климата и патогенные грибы
В крупном обзоре влияния климатических изменений и стихийный бедствий на грибковые патогены и риски распространения микозов исследователи рассмотрели адаптацию грибов к повышению температуры на Земле и пришли к выводу, что грибы становятся толерантными к росту температур и становятся более вирулентными.
Изменение климата создает условия, способствующие появлению новых грибковых патогенов, и побуждает грибы адаптироваться к ранее негостеприимным условиям, таким как загрязненные места обитания и городские районы, что приводит к географическому распространению некоторых грибов в традиционно неэндемичных районах, – пишут авторы обзора.
Изменение климата также способствует увеличению частоты и серьезности стихийных бедствий, которые могут спровоцировать вспышки грибковых заболеваний и увеличить распространение патогенов. Более того, становится все более очевидным, что рост глобальных температур оказывает существенное влияние на возникновение и повторное распространение других инфекционных заболеваний.
Патогенные грибы — грибы, которые вызывают заболевания у людей или других организмов. Изображение: www.isaaa.org
Напомним, что изменение климата относится к долгосрочным изменениям температур и погодных условий, которые нарушают работу экологических систем во всем мире, приводя к изменениям в глобальном распределении патогенов, хозяев и резервуаров болезней.
Это интересно: Что скрывается за проклятием фараонов?
Это относится в том числе и к микозам – инфекционным заболеваниям, вызываемым паразитическими грибками. Так, повышение температур уже способствовало распространению эндемичных грибковых заболеваний, таких как кокцидиоидомикозы и гистоплазмоз.
Микозы – глобальная угроза
Прежде чем окончательно испугаться распространения патогенных грибов отметим, что заражение такими грибами как кандида, аспергиллы и является смертельной угрозой в первую очередь для людей с ослабленным иммунитетом. Здоровым людям, к счастью, редко приходится беспокоиться о заражением грибковой инфекцией, а подавляющее большинство потенциально патогенных грибов плохо себя чувствуют внутри человеческого тела. Но, это, предупреждают эксперты, в будущем может измениться.
Как показали результаты работы, недавно опубликованной в журнале Proceedings of the National Academy of Sciences, при более высокой температуре окружающей среды некоторые виды патогенных грибов приобретают изменения в использовании и регулировке определенных генов.

Человечество вряд ли готово к пандемии грибковых заболеваний, полагают специалисты. Изображение: i.natgeofe.com
Эти подвижные элементы ДНК, вероятно, способствуют адаптации к окружающей среде и большей вирулентности. Это означает, что в будущем инфекционные грибковые заболевания могут стать более распространенными, так как тепловой стресс увеличивает количество происходящих мутаций, – говорит один из авторов исследования Асия Гуса из Университета Дьюка.
Важно понимать, что грибковые заболевания не являются инфекционными в нашем привычном понимании – мы не передаем грибки друг другу, однако грибные споры находятся в воздухе, а значит мы постоянно их выдаем. К счастью, на сегодняшний день наша иммунная система в состоянии с ними бороться. К тому же грибные споры крупнее вирусов, а значит защитные маски времен пандемии СOVID-19 будут крайне эффективны.
По теме: Могут ли грибы превратить людей в зомби? Объясняем на примере «The Last of Us»
Исследователи отмечают, что сегодня число грибковых заболеваний растет в основном из-за увеличения числа людей с ослабленной иммунной системой или сопутствующими заболеваниями. Тревогу вызывает также тот факт, что патогенные грибы быстро адаптируются к климатическим изменениям и росту температур.
Так, в ходе работы авторы нового исследования выяснили, что тепловой стресс у патогенных грибов C. deneoformans значительно ускорил мутации – после 800 поколений выращивания в лабораторной среде частота мутаций была в пять раз выше у грибов, выращенных при температуре тела 37 градусов Цельсия, по сравнению с грибами, выращенными при температуре 30 градусов.

Патогенные грибы адаптируются к температуре человеческого тела. Изображение: insideclimatenews.org
Мобилизация переносимых элементов также, по-видимому, была выше у грибов, живущих на мышах, чем в лабораторных культурах. Авторы исследования подозревают, что дополнительные проблемы выживания животных с ослабленной иммунной системой могут привести к тому, что мутации будут происходит все чаще, а вирулентность патогенных грибов – сильнее. Еще больше тревоги вызывает рост устойчивости грибковых инфекций к антибиотикам.
Хотите всегда быть в курсе последних новостей из мира науки и высоких технологий? Подписывайтесь на наш канал в Telegram – так вы точно не пропустите ничего интересного!
Немаловажно и то, что в мире наблюдается снижение средней температуры тела у людей, что, вероятно, вызвано уменьшением числа хронических инфекций и воспалительных процессов наряду с повышением уровня жизни. Таким образом, изменение климата может повысить патогенность грибов для человека, приводя в соответствие температурные предпочтения грибов и потенциальных хозяев-людей.
Это приводит нас к увеличению числа генетических изменений, некоторые из которых, предположительно, могут привести к повышению устойчивости к жаре, а другие, возможно, к большему потенциалу возникновения болезней. Бактерии и вирусы являются причиной смертельных глобальных пандемий и назойливых инфекций. Но патогены, с которыми нам пока не приходилось сталкиваться в такой степени — это грибы.

Микозы постепенно обретают лекарственную устойчивость. Изображение: thred.com
Мы знаем, что многие грибковые инфекции могут сохраняться, а затем возвращаться с потенциальными генетическими изменениями. И если патогенные грибы адаптируются к изменению климата быстрее, чем ожидалось, этой проблеме следует уделить как можно внимания, –говорит заведующий кафедрой молекулярной микробиологии и иммунологии Университета Джона Хопкинса Артуро Касадевалл.
Изменения в экосистемах
Грибковые патогены растений эволюционируют в связи с изменением климата и, помимо прочего, угрожают мировой продовольственной безопасности. Изменения в погодных условиях продолжают разрушать экологические системы и изменять глобальное распределение источников болезней, патогенов и хозяев.
Имеющиеся на сегодняшний день модели предсказывают, что изменения в грибковых сообществах будут способствовать распространению сапротрофных грибов или сапрофагов – живых существ, которые получают питательные соединения из остатков погибших животных или отходов их жизнедеятельности.
Патогенные грибы – реальная угроза. Изображение: www.trendbullet.in
Вам будет интересно: В США опасный грибок заражает человеческий мозг. Что нужно знать?
Поскольку патогенные грибы приспосабливаются к одним факторам внешней среды, таким как повышение температуры, то могут противостоять другим, таким как тяжелые металлы, радиоактивные изотопы и рН-стресс. Это позволяет им распространяться в кислой среде и на загрязненных пустырях. Эволюционное давление, оказываемое эффектом теплового острова в городских районах, по-видимому, способствует более быстрой адаптации грибов.
Загрязненные водоемы также могут быть источником грибковых инфекций и угрожать системам здравоохранения. Многие грибы, в том числе аспергиллы и некоторые виды мукормицетов, могут разрушать пластик и являются патогенными для человека. Таким образом, накопление микропластика может способствовать росту грибков и устойчивости к противогрибковым препаратам.

Патогенные грибы могут стать сильнее по мере потепления климата. Изображение: cff2.earth.com
Более того, ранее распространенные грибковые заболевания, такие как гистоплазмоз и кокцидиоидомикозы, расширили географию своего присутствия. Число патогенов растений также увеличивается и представляет серьезную угрозу продовольственной безопасности. Несмотря на то, что в сельском хозяйстве все чаще используются фунгициды, имеются данные о случаях резистентности к противогрибковым препаратам.
Не пропустите: Как грибок зомбирует мух и заставляет выполнять безумные действия
Поскольку последствия изменения климата ощущаются во всем мире, микологи и исследователи в области общественного здравоохранения высказывают опасения, что повышение температуры способствует появлению новых патогенных грибов и изменяет распределение и распространенность болезней. А это, согласитесь, тревожный знак для всех нас.














